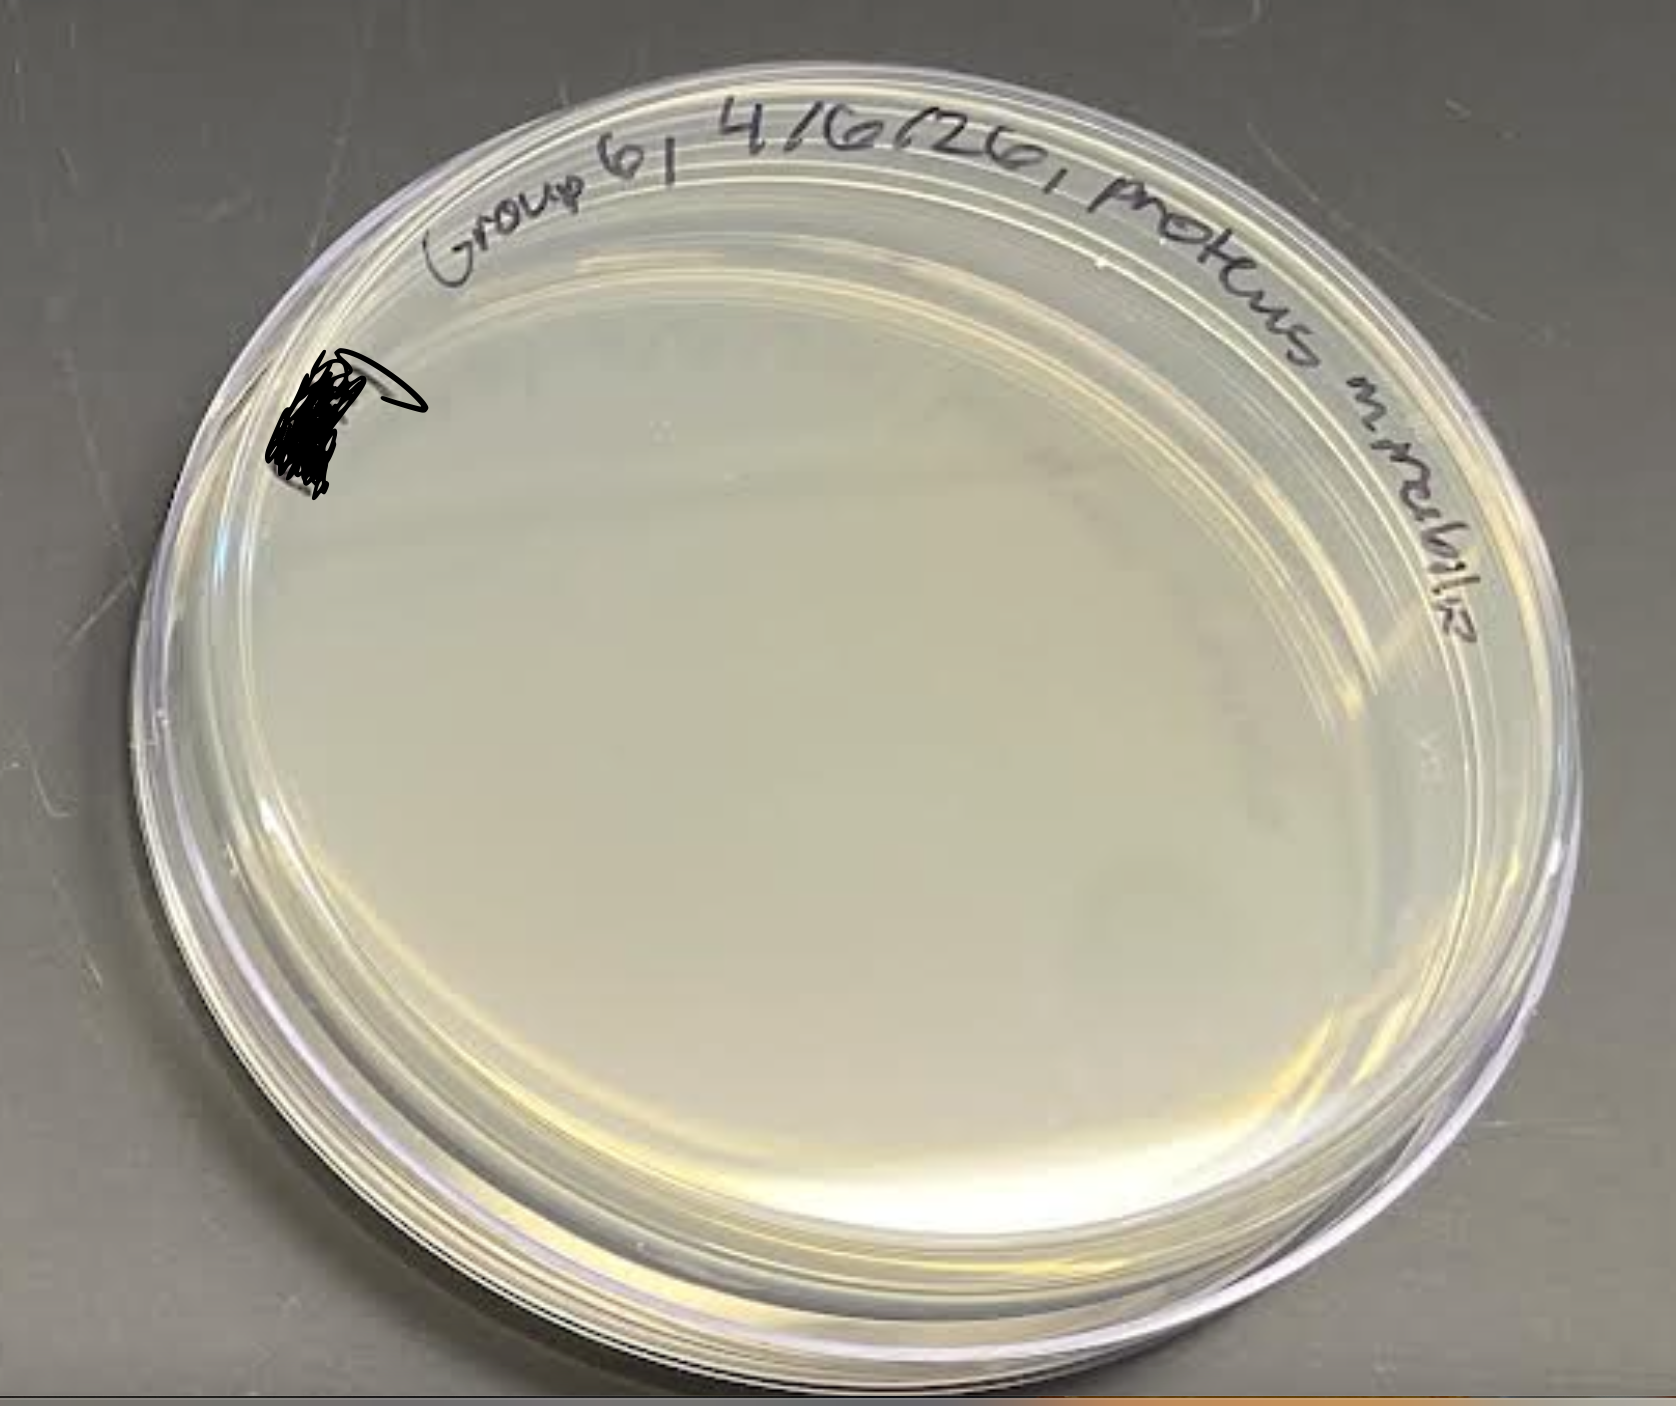
<p>What is this plate’s name, selective agent, results and everything about it?</p>
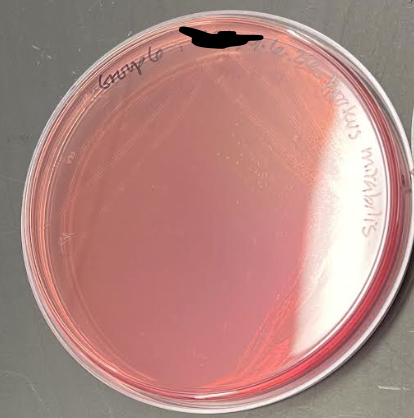
<p>What is the plate’s name, selective agent, selects for, differential agents, differentiates between, and everything about it?</p>
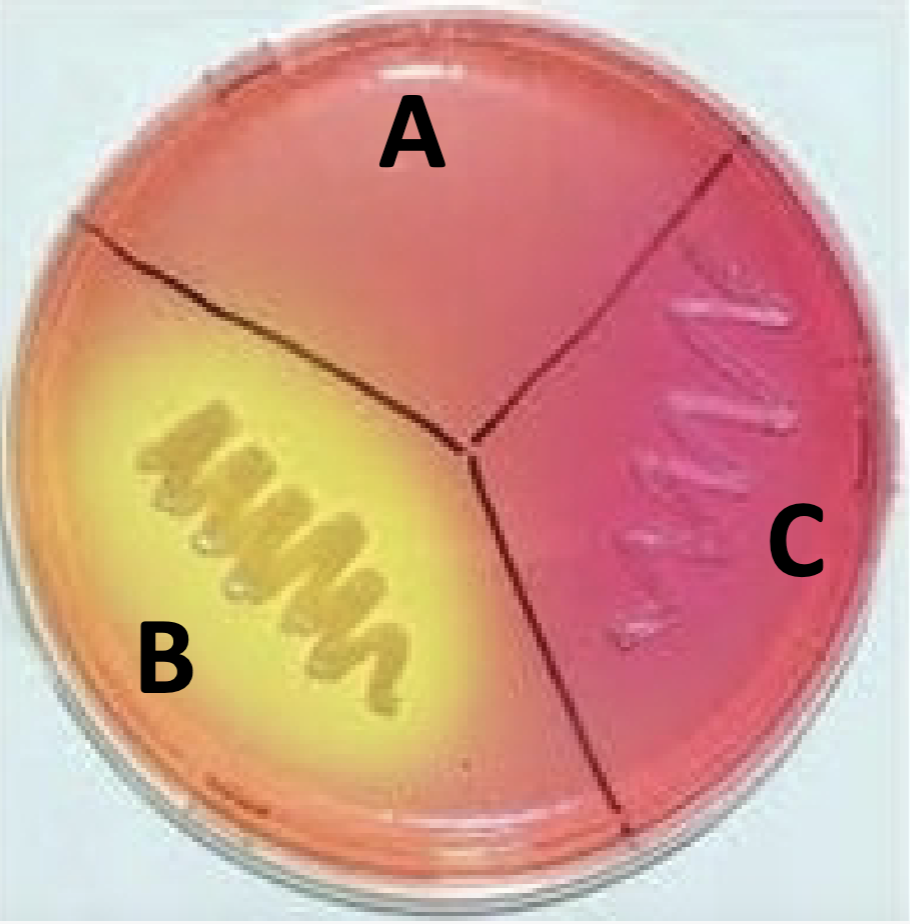
<p><strong>Name:</strong> Mannitol Salt Agar(MSA)</p><p><strong>SELECTIVE AGENT:</strong> 7.5% NaCl</p><p><strong>SELECTS FOR</strong>: salt tolerant bacteria (halophiles)</p><p><strong>DIFFERENTIAL AGENTS</strong>:</p><p>1<u>. Mannitol: </u>fermentable sugar</p><p><u>2. </u><span style="color: red;"><u>Phenol Red:</u></span><u> </u>pH indicator</p><p>- Acidic = <mark data-color="#d5d714" style="background-color: rgb(213, 215, 20); color: inherit;">yellow</mark></p><p>- Neutral = <span style="color: red;">red</span></p><p>- Basic = <span style="color: rgb(210, 27, 224);">shocking pink</span> (like a fuschia)</p><p><strong>DIFFERENTIATES BETWEEN:</strong></p><p>- <u>Mannitol fermentors</u>:<mark data-color="#e9d91b" style="background-color: rgb(233, 217, 27); color: inherit;"> yellow </mark>around the colony(halo)</p><p>- <u>Non-mannitol fermentors</u>: <span style="color: red;">red </span>or <span style="color: rgb(247, 14, 243);">shocking pink</span> around the colony</p><p>Extra info: WHEN AN ORG IS NOT SALT TOLERANT WE CAN’T TELL IF IT IS MANNITOL OR NON-MANNITOL, JUST THAT IT’S NON-SALT TOLERANT</p><p></p>
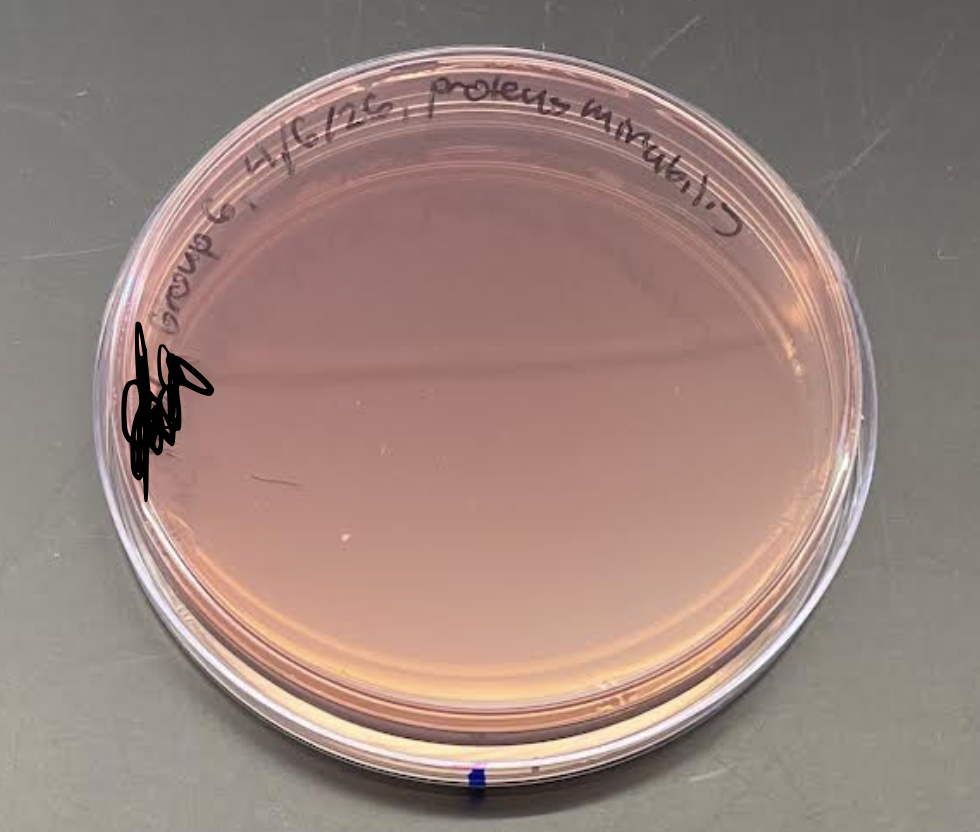
<p>What is the plate’s name, selective agents, select for, differential agents, differentiates between, and everything about it?</p>
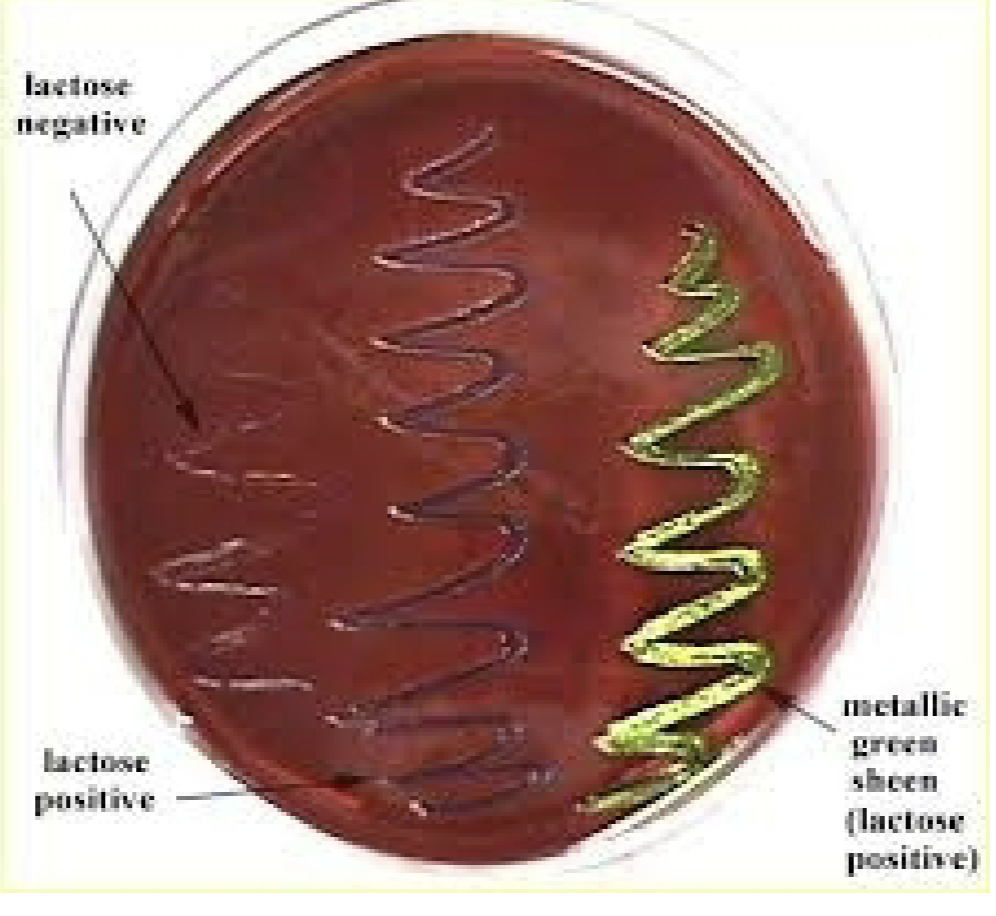
<p><strong>Name: </strong>Eosin Methylene Blue Agar (EMB) - has a dark jolly rancher purple</p><p><strong>SELECTIVE AGENT:</strong></p><ol><li><p>Eosin</p></li><li><p>Methylene Blue</p></li></ol><p><strong>SELECTS FOR: </strong>Gram (-) bacteria</p><p><strong>DIFFERENTIAL AGENTS:</strong></p><ul><li><p><u>Lactose: </u>fermentable sugar</p></li><li><p><u>Eosin</u></p></li><li><p><u>Methylene Blue</u></p></li></ul><ol><li><p><u>Lactose fermentors: </u>colonies are <span style="color: rgb(105, 4, 155);">dark purple</span>, and leads to a <span style="color: rgb(59, 218, 26);">green metallic sheen</span>(metal looking green)</p></li><li><p><u>Non-lactose fermentors: </u>colonies are colorless or <span style="color: rgb(186, 40, 213);">pink</span></p></li></ol><p>Extra info:</p><p>MAC is still more accurate</p><ul><li><p>Gram (+) if it didn’t grow at all</p></li></ul><p></p>
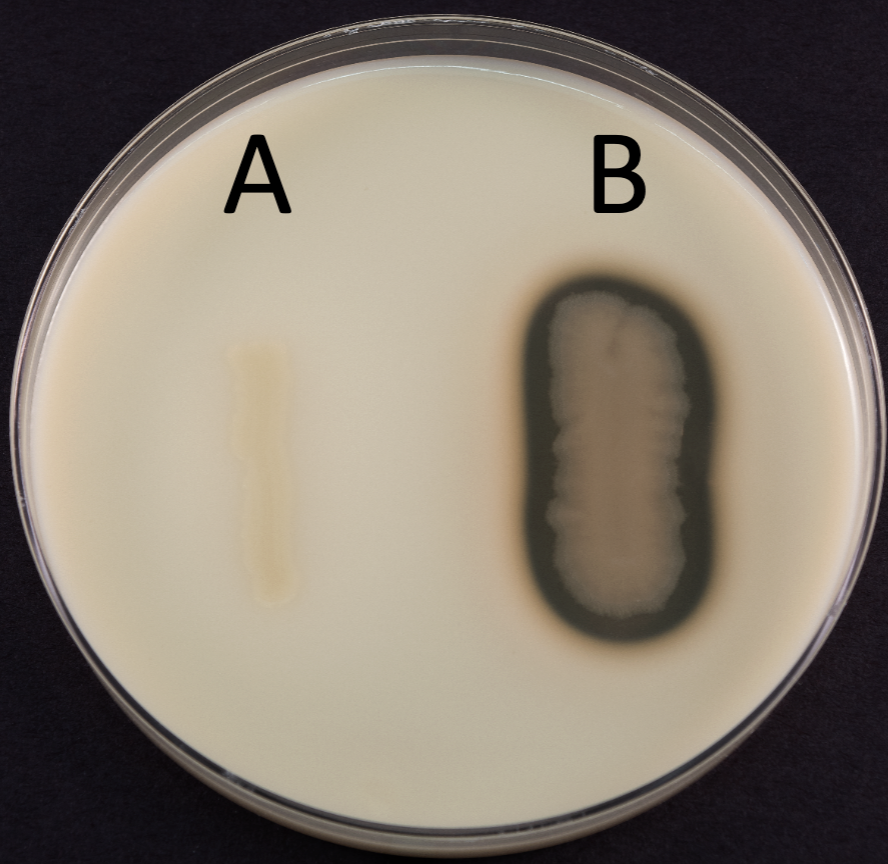
<p><strong>Name: </strong>Casein Hydrolysis Test</p><p><strong>EXOENZYME TESTED: </strong>Caseinase</p><p><strong>MEDIA: </strong>Skim milk agar(is like a milk color on plate)</p><p><strong>INOCULATION GUIDE: </strong>loopful streak</p><p><strong>INCUBATION: </strong>37°C for 48 hrs</p><p><strong>Theory:</strong></p><p>Casein(substrate, white) ——→ caseinase —> amino acids(clear, broke down into this)</p><p><strong>RESULTS:</strong></p><p>(+): clear around the growth (since you released casein to be around you)</p><p>(-): white around the growth</p><p>REVIEW TABLE’S LAB RESULT PLATE TOO</p>
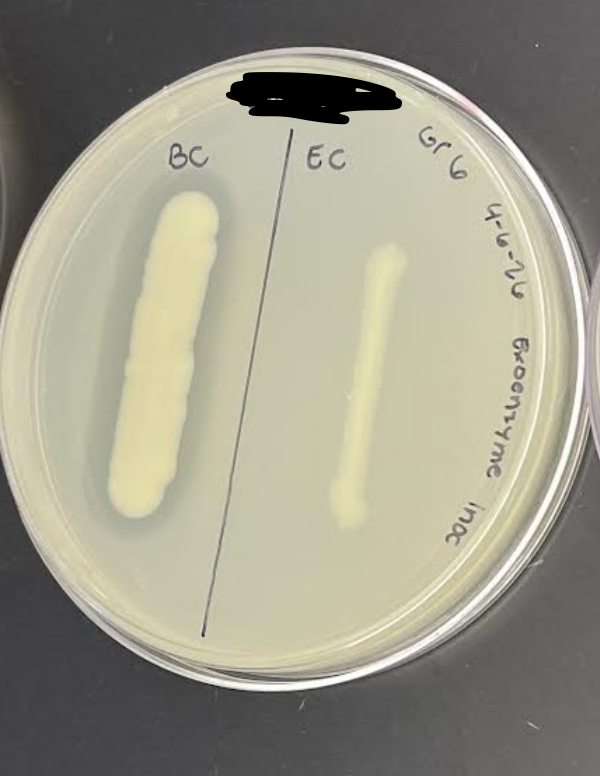
<p>What is the plate used here, what kind of test is conducted, media, incoulation, incubation, theory, results and everything else about it?</p>

1/24
Looks like no tags are added yet.
Name | Mastery | Learn | Test | Matching | Spaced | Call with Kai |
|---|
No analytics yet
Send a link to your students to track their progress
What is selective media?
Contains chemicals that PREVENT the growth of the desired bacteria without inhibiting the growth of the desired bacteria.
What is enrichment media?
Contains chemicals that ENHANCE the growth of the desired bacteria, other bacteria will grow, but the growth of the desired bacteria will be increased.
What is differential media?
Contains various nutrients that allow us to distinguish one bacteria from another based on how they metabolize.
What is this plate’s name, selective agent, results and everything about it?
Name: Phenylethyl Alcohol Agar Plate(PEA)
SELECTIVE AGENT: Phenylethyl Alcohol
Disrupts membrane —> P(phosphorus) leaks out
—→ stops DNA synthesis
SELECTS FOR: Gram (+) bacteria
RESULTS: Growth = Gram (+), No Growth = Gram (-)
What is the plate’s name, selective agent, selects for, differential agents, differentiates between, and everything about it?
Name: Mannitol Salt Agar(MSA)
SELECTIVE AGENT: 7.5% NaCl
SELECTS FOR: salt tolerant bacteria (halophiles)
DIFFERENTIAL AGENTS:
1. Mannitol: fermentable sugar
2. Phenol Red: pH indicator
- Acidic = yellow
- Neutral = red
- Basic = shocking pink (like a fuschia)
DIFFERENTIATES BETWEEN:
- Mannitol fermentors: yellow around the colony(halo)
- Non-mannitol fermentors: red or shocking pink around the colony
Extra info: WHEN AN ORG IS NOT SALT TOLERANT WE CAN’T TELL IF IT IS MANNITOL OR NON-MANNITOL, JUST THAT IT’S NON-SALT TOLERANT

What is the plate’s name, selective agents, select for, differential agents, differentiates between, and everything about it?
Name: MaConkey Agar(MAC) Plate)
SELECTIVE AGENTS:
Bile Salts: Inhibits Gram (+) bacteria
Crystal Violet: inhibits Gram (+)
SELECTS FOR: Gram (-) bacteria
DIFFERENTIAL AGENTS:
Lactose: fermentable sugar
Neutral Red: pH indicator
Neutral or basic = colorless
Acidic = red
DIFFERENTIATES BETWEEN:
Lactose fermentors: colonies turn a shade of red (or possibly pink)
Non-lactose fermentors: colonies remain opaque or colorless
ALWAYS TRUST MaConkey AND IF THERE’S NO GROWTH = GRAM(+) NOTHING ELSE


What is the plate’s name, selective agents, select for, differential agents, differentiates between, everything about it?
Name: Eosin Methylene Blue Agar (EMB) - has a dark jolly rancher purple
SELECTIVE AGENT:
Eosin
Methylene Blue
SELECTS FOR: Gram (-) bacteria
DIFFERENTIAL AGENTS:
Lactose: fermentable sugar
Eosin
Methylene Blue
Lactose fermentors: colonies are dark purple, and leads to a green metallic sheen(metal looking green)
Non-lactose fermentors: colonies are colorless or pink
Extra info:
MAC is still more accurate
Gram (+) if it didn’t grow at all

What is the plate’s name, differentiates between, everything about it?
Name: Blood Agar Plate(BAP) - red, blood color
ENRICHED WITH: 5% defibrinated sheep blood
DIFFERENTIAL AGENT: 5% defibrinated sheep blood
DIFFERENTIATES BETEWEEN:
Beta-hemolysis: complete hemolysis (meaning there is a clear zone around the colony).
Alpha-hemolysis: partial hemolysis (meaning it is cloudy or green around the colony)
Gamma-hemolysis: no hemolysis, no change around colony.
TRICK TO RMB: Beta = bad, Alpha = alright, and Gamma = good.
Hold up to light to see how to differentiate the results.
STUDY RESULTS FROM LAB MANUAL PAGE AROUND 100 SOMETHING, and extra pictures taken from his review.

What are enzymes and the two different types?
DEFINITION: Are proteins that catalyze biological reactions
Endoenzymes: function inside the cell
Exoenzymes: function outside the cell(so they’re released from the cell to catalyze reactions out of the cell

What is the plate used here, what kind of test is conducted, media, inoculation guide, incubation, theory, results, and everything else about it?
Name: Casein Hydrolysis Test
EXOENZYME TESTED: Caseinase
MEDIA: Skim milk agar(is like a milk color on plate)
INOCULATION GUIDE: loopful streak
INCUBATION: 37°C for 48 hrs
Theory:
Casein(substrate, white) ——→ caseinase —> amino acids(clear, broke down into this)
RESULTS:
(+): clear around the growth (since you released casein to be around you)
(-): white around the growth
REVIEW TABLE’S LAB RESULT PLATE TOO

What is the plate used here, what kind of test is conducted, media, incoulation, incubation, theory, results and everything else about it?
Name: Starch Hydrolysis Test
EXOENZYME TESTED: amylase
MEDIA: Starch agar plate
INOCULATION GUIDE: loopful streak
*After incubation: add iodine over the plate(this will bind to the starch)
INCUBATION: 37°C for 48 hrs
THEORY:
Starch —→ amylase —> simple sugars(is broken down into this)
*Add iodine: starch = blue/black, simple sugar = yellow
RESULTS:
(+): yellow around growth (like a halo)
(-): blue/black around growth
Extra info:
BC = postive because it is yellow around
EC lights up, but not positive
WE ALWAYS LOOK AROUND THE COLONY, LIGHTING UP DOESN’T MATTER.


What is the test name, purpose, application, media, theory and everything else about it?
Name: Catalase Test
PURPOSE: to determine if your organism has the enzyme catalase(meaning it breaks down hydrogen peroxide)
APPLICATION: differentiates GPC (gram (+) cocci)
(+): Staphylococcus and Micrococcus
(-): Streptococcus and Enterococcus
MEDIA: TSA plate
INOCULATING GUIDE: loopful streak (could do a quadrant or just one line)
INCUBATION: 37°C for 48 hrs
THEORY:
2H2O2(substrate,hydrogen peroxide) —> catalase —> 2H2O + O2 (bubbles)
*After incubation: use a toothpick to put the bacteria on a slide
Add 1 drop of H2O2(hydrogen peroxide)
RESULTS:
(+): bubbles
(-): no bubbles

What is the the test name, purpose, media, theory, and everything else about it?
Name: Oxidase Test
PURPOSE: to determine, if your organism has the enzyme cytochrome C oxidase.
MEDIA: TSA plate
INOCULATING GUIDE: loopful streak
INCUBATE: 37°C for 48 hrs
THEORY:
After incubation, use a toothpick to put the bacteria on a piece of filter paper
Add 1 drop of oxidase reagent(this will detect cytochrome C oxidase)
RESULTS:
(+): purple (within 30 seconds)
(-): color of the bacteria

What is the test name, purpose, media used, theory and everything about it?
Name: Sugar Fermentation Test
PURPOSE: to determine if your organism ferments in desired sugar into an acid or acid and gas(or not at all).
MEDIA: PR(Phenol Red) _________ broth (blank means it depends on what carbohydrate is there)
Fermentable sugar (depends on what the sugar is)
Phenol Red: pH indicator
Acidic = yellow
Neutral = red
Basic = shocking pink
Durham tube: traps gas(upside down glass tube, red cap, gas accumulates inside tube producing a bubble).
INOCULATION GUIDE: loopful incoculation
INCUBATION: 37°C for 48 hrs
THEORY:
Sugar is fermented —> acid (reacts with Phenol Red)
RESULTS:
(+) For Acid ONLY: yellow tube, no gas bubble
(+) For Acid and Gas: yellow tube, gas bubble
(-) For Acid and Gas: red or shocking pink tube, no gas bubble.

What are the two different lactose fermentors, and what is a late lactose fermentor?
Requires 2 enzymes:
B-galactoside permease(beta-galactoside permease): allows lactose to enter the cell
B-galactosidase:(beta-galactosidase): breaks lactose —> glucose and galactose forms.
Late lactose fermentors: ONLY have B-galactosidase.

What is the test name, purpose, media used, inoculation guide, theory and everything about it?
Name: ONPG Test
PURPOSE: to detect B-galactosidase in an organism.
MEDIA: TSA plate(tryptic soy agar, previously grown)
INOCULATION GUIDE:
* Add a heavy inoculum from previously grown plate to test tube with 1mL of water(scrap A LOT of the bacteria)
* Add ONPG Tablet
INCUBATION: 37°C for 48 hrs.
THEORY: ONPG
Is a synthetic substrate of B-galactosidase, does not require a permease to enter cell.
ONPG(substrate) —> B-galactosidase(breaks)—> O-nitrophenol(yellow enzyme)
RESULTS:
(+): yellow
(-): clear or foggy
Note:
ONPG does not require permease to enter the cell.

What is the IMVIC test/what does each part of IMVIC stand for?
IMVIC: is a series of tests to differentiate GNRs.
I: Indole Production Test
M: Methyl Red Test
V: Voges-Proskauer Test
C: Citrate Utilization Test

What is the name of the test, purpose, the media, inoculation guide, incubation, theory, results, and everything about it?
Name: Indole Production Test
PURPOSE: to determine if your organism has the enzyme tryptophanase (produces indole)
MEDIA: Tryptone broth —> clear color
INOCULATION GUIDE: loopful
INCUBATION: 37°C for 48 hrs.
THEORY: Tryptophan(substrate) —> tryptophanase—> pyruvic acid + NH3 + indole
*After incubation, add 5 drops of kovac’s reagent
indole + kovacs reagent (yellow)
RESULTS:
*After adding 5 drops of kovacs reagent:
(+): pink on top(has the enzyme tryptophanase)
(-): yellow on top


What is the name of the test, the purpose, media, inoculation guide, incubation, theory, and results?
Name: Methyl Red Test
PURPOSE: to determine if your organism ferments glucose into mixed acids.
MEDIA: glucose supplemented nutrient broth
INOCULATION GUIDE: loopful
INCUBATION: 37°C for 48 hrs.
THEORY: glucose is fermented into —> organic acids
After incubation, add 5 drops of
Methyl Red: pH indicator
- Acidic: red
- Neutral or basic: yellow
RESULTS:
(+): red
(-): yellow


What is the name of the test, purpose, media, inoculation guide, incubation, theory, and results?
Name: Voges-Proskauer Test
PURPOSE: to determine if your organism ferments glucose into a neutral product called acetoin.
MEDIA: glucose supplemented nutrient broth
INOCULATION GUIDE: loopful
INCUBATION: 37°C for 48 hrs.
THEORY:
glucose is fermented —> neutral product acetoin
After incubation, to detect acetoin, add:
Alpha-naphthol(8 drops)
KOH(4 drops) - potassium hydroxide
RESULTS: NEED TO WAIT AT LEAST 15-30 MIN. AFTER ADDING KOH
(+): red
(-): yellow (didn’t have acetoin)


What is the name of the test, purpose, media used, inoculation guide, incubation, theory and result?
Name: Citrate Utilization Test
PURPOSE: to determine if your organism can use Na citrate as the only carbon source
MEDIA: Simmons citrate agar slant (greenish color)
Na citrate: only carbon (C) source
Ammonium phosphate: only (N) nitrogen source
Bromthymol Blue: pH indicator
- Acidic = yellow
- Neutral = green
- Basic = blue
INOCULATION GUIDE: loopful streak in slant
INCUBATION: 37°C for 48 hrs
THEORY:
If your organism can use Na citrate and ammonia phosphate as the only C and N source (produces ammonia)
—> NH3(basic) - reacts with bromthymol blue
RESULT:
(+): growth, blue (can use Na citrate)
(-): no growth, green


What is the name of the test, purpose, the media, incoculation guide, incubation, theory, and results?
Name: Gelatin Hydrolysis Test
PURPOSE: To detect the present of gelatinase(breaking down gelatin).
MEDIA: Nutrient broth
INOCULATION GUIDE: loopful
*After incubation(1st incubation): add gelatin strip, and re-incubate.
INCUBATION: 37° for 48 hrs. (2x) HAVE TO DO THIS TWICE
THEORY:
Gelatin(protein, substrate, solid, at room temperature)-→ gelatinase(enzyme) —> amino acids(liquid)
Gelatin strip is a clear blue plastic(underneath the coat of green), and covered with green gelatin(like a sage green, flexible, on both sides).
RESULTS:
(+): strip is clear blue
(-): strip is green(sage green, same color as the top)
*Basically wherever gelatin is working, gelatin will fall off, so you dip it into the broth to figure it out.

What kind of test is this, purpose, application, it’s media, inoculation guide, incubation, theory, and results?
Name: Urea hydrolysis Test
PURPOSE: to detect the presence of urease(enzyme)
APPLICATION: helps differentiate GNR's (gram (-) rods)
MEDIA: TSA plate (previously grown)
1 mL tube of water(sterile water)
Urea tablet(look like yellow vitamin tablets)
- yeast extract: nutrients
- Urea: substrate
- Phenol red: pH indicator
INOCULATION GUIDE: heavy inoculation into water(pick up about 3-4 colonies to transfer in the test tube)
Add urea tablet to 1mL of water
INCUBATION: 37°C for 48 hrs.
THEORY:
Urea(substrate in tablet) —> urease —> 2NH3(basic, ammonia) + CO2
RESULTS:
(+): shocking pink(reacts with phenol red)
(-): no color change or yellow(or like a bright yellow, salmon, soft pink/peach color)


What is the name of the test, purpose, application, media, inoculation guide, incubation, theory, and results?
Name: Lysine Decarboxylase Test(LDC):
PURPOSE: to detect the presence of lysine decarboxylase.
APPLICATION: to help differentiate GNRs (Gram negative rods)
MEDIA: Mollers Lysine Decarboxylase media(tea color can identify on practicum by oil on top)
peptone: nutrients
glucose: induce fermentation
lysine: amino acid substrate for lysin decarboxylase
- Bromcresol purple: pH indicator
Acidic = yellow(like a soft baby yellow)
Neutral = gray(tea color, isn’t really consistent)
Basic = purple (vibrant purple)
INOCULATION GUIDE: loopful
layer with mineral oil: keeps O2 out, induces fermentation (so about 1 mL of oil, will be on top of media and block off O2).
INCUBATION: 37°C for 48 hrs. *MUST DO FULL 48 HOURS
THEORY:
- Decarboxylation will occur if:
Amino acid substrate is present
There is a drop in pH: glucose + mineral oil —> induces fermentation
Lysine —→ lysine decarboxylase —→ cadaverine(basic) + CO2
RESULTS:
(+): purple(vibrant, reacts with bromcresol purple)
(-): yellow or no change(gray)


What is the name of the test, purpose, application,it’s media, inoculation guide, incubation, theory, and results including what is H2S production?
Name: Kligler Iron Agar(KIA) Test
PURPOSE: differential screening media based on:
glucose fermentation
lactose fermenetation
H2S (hydrogen sulfide) production
APPLICATION: differentiate GNRs(gram(-) rods)
MEDIA: Kligler Iron Agar Slant
0.1% glucose: fermentable sugar, low concentration (K/A) only glucose
1% lactose: fermentable sugar, high concentration(yellow, yellow, K/K)
0.02% ferrous sulfate: detects H2S —> black color.
MEDIA:
Phenol red: pH indicator
Nutrient agar(slant)
INOCULATION GUIDE: loopful streak on slant surface,
needle stab the butt(then remove)
INCUBATION: 37°C for 48 hrs/
THEORY AND RESULTS;
Ferments ONLY glucose:
Yellow butt: acid reacts with Phenol Red
Red Slant: after low concentration of glucose is used up, amino acid oxidation occurs —> produces ammonia(basic)
Ferments lactose OR lactose and glucose:
Yellow butt and slant: acid reacts with phenol red, so there is a high concentration of lactose.
Does NOT ferment either sugar:
Red or shocking pink butt and slant(so both red slant and butt, doesn’t produce any acid, so nothing should be yellow).
H2S Production:
(+): black percipitant(like a black product)
Gas production:
(+): butt lift (like there is a lift in the medium)
Extra info:
Break in yellow tube, ferments into acid as well as gas(no black = (-) for H2S)
black in bottom = H2S production
tube with red top, black middle, yellow bottom ONLY ferments glucose(+) for H2S production.
